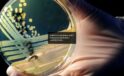

Dünya’nın en büyük ithalat fuarı ve Çin’in en prestijli fuarlarından biri olan Çin Uluslararası İthalat Fuarı (CIIE), 2024 yılında da önemli iş bağlantılarına sahne oldu.
Türkiye Milli Katılım organizasyonu, Ege İhracatçı Birlikleri (EİB) liderliğinde gerçekleştirilirken, Türkiye’den 15 firma fuara katılım sağladı.
Bu firmaların 13’ü gıda sektöründe faaliyet gösterirken, diğer iki firma farklı sektörlerde Türkiye’yi temsil etti.
Ege İhracatçı Birlikleri Koordinatör Başkanı Jak Eskinazi, “Çin Uluslararası İthalat Fuarı, Çin Devlet Başkanı Şi Cinping tarafından bizzat planlanan, önerilen ve teşvik edilen önemli bir etkinlik. Fuarın açılışı Çin Halk Cumhuriyeti Başbakanı Li Qiang’ın katılımı ile gerçekleştirildi. 129 ülkeden 3.496 katılımcı fuarda yer aldı. Türkiye’den Çin’e yapılan ihracat 2024 yılının Ocak – Ekim döneminde yüzde 4,8 artışla 2 milyar 598 milyon dolara yükseldi. Çin’e ihracatımızı uzun vadede 12 milyar dolara çıkarmak istiyoruz. Yüksek Katma Değerli Tarım Ürünleri Ticaretinin Kolaylaştırılması konulu bir toplantıya da katıldık. Bu toplantı, Çin ile tarım ürünleri ticaretinde yeni fırsatların kapısını aralamak adına büyük önem taşıyor. Önümüzdeki yıl milli katılım ile fuara katılan firmalarımızın sayısının artması için devlet desteğinin artırılması, sektör özelinde tanıtımlar yapılması planlarımız var. Kozmetik sektörü bunlardan biri.” dedi.
Nanjing Belediye Başkanı ile Yiwu Belediye Başkanı ziyareti
Fuarda standımızı Nanjing Belediye Başkanı ile Yiwu Belediye Başkan Yardımcısının ziyaret ettiğini ifade eden Ege İhracatçı Birlikleri Koordinatör Başkan Yardımcısı ve Ege Demir ve Demirdışı Metaller İhracatçıları Birliği Başkanı Yalçın Ertan “Daha önce İzmir’I ziyaret eden ve çok iyi izlenimlerle ayrıldığını belirten Nanjing Belediye Başkanı ile önümüzdeki aylarda İzmir ile kardeş şehir protokolünün imzalanması için bir ziyaret gerçekleştireceğimizi ilettik. Ayrıca Yiwu Belediye Başkan Yardımcısı, İzmir’I ve Ege Bölgesi’ni çok merak ettiklerini Yiwuli vatandaşlara buralara turistik seyahat düzenlemeleri için teşvik edeceğini belirtti.” diye konuştu.
Export Bahrain ile işbirliği protokolü
Fuar sırasında bir çok kurumla görüşmeler gerçekleştirildiğini, Export Bahrain kurumu ile “Mutabakat Zaptı” imzalandığını açıklayan Başkan Ertan sözlerine şöyle devam etti: “Bahreyn Sanayi ve Ticaret Bakanlığına bağlı olarak 2018 yılında kurulmuş, Bahreynli işletmelerin ticaretini geliştirmeyi amaçlayan Export Bahrain kurumunun üyeleri ile EİB üyeleri arasında ticaret hacminin geliştirmesinin hedeflendiği “Mutabakat Zaptı” ile firmalarımızın Bahreyn’e olan ihracatının artırılmasını hedefliyoruz” dedi.
Canlı yayınlar 1 milyon kişi tarafından takip edildi
Ege Deri ve Deri Mamulleri İhracatçıları Birliği Başkanı Erkan Zandar, “Fortune 500 listesinde yer alan 297 firmanın fuarda stantı vardı. CIIE 2024 katılımcıları tarafından, bir önceki yıla göre %2 artışla, toplamda 80,1 milyar dolar değerinde iş bağlantısı gerçekleştirildi. Fuar süresince wechat hesabımızdan katılımcı firmalarımız ve fuar sırasında gerçekleştirdiğimiz etkinliklerimiz ile ilgili paylaşımlar yaptık. 7 Kasım ve 8 Kasım’da yaptığımız canlı yayınlar 1 milyon kişi tarafından takip edildi. Yil boyunca EIB sosyal medya hesaplarımız üzerinden firmalarımızın Çin pazarında tanıtımlarını yapmaya devam edeceğiz. WeChat , LittleRedBook , TikTok hesaplarımız üzerinden, ekibimiz ve anlaşmalı influencerlarımız ile hazırlayacağımız içerikler ile Türk markalarının değerini Çinli alıcılar ile buluşturmayı hedefliyoruz.” diye konuştu.
Türkiye’nin gastronomi zenginliği ön plana çıktı
Ege İhracatçı Birlikleri Sürdürülebilirlik ve Organik Ürünler Koordinatörü ve Ege Kuru Meyve ve Mamulleri İhracatçıları Birliği Başkanı Mehmet Ali Işık, Çin’in gıda ihracatçıları için büyük fırsatlar sunduğunu ifade ederek fuar boyunca, kuru meyve, zeytin, zeytinyağı, fındık ve antep fıstığı gibi Türk lezzetleri ziyaretçilerin tadım etkinlikleri yapıldığını belirterek “Tadım yaptırdığımız ürünlerle hazırlanan özel atıştırmalıklar, düzenlenen tadım etkinliklerinde büyük ilgi gördü.” Diye konuştu.
Ticaret Müşavirliği tadım etkinliği
Ege Hububat Bakliyat ve Yağlı Tohumlar İhracatçıları Birliği Başkanı Muhammet Öztürk, Ticaret Müşavirliğimizin ev sahipliğinde, Çin’li influencerlar, gazeteciler, ithalatçıların katılımıyla özel bir tadım etkinliği gerçekleştirildiğini ifade ederek “Fuar öncesinde “Turkish Tastes” Turquality projemiz kapsamında daha önce ABD’de organize ettiğimiz Türk yemekleri tadım etkinliğinin bir benzerini Çin’de Başkonsolosumuz ve Ticaret Müşavirlerimizin desteği ile gerçekleştirdik” diye konuştu.
Fuarın destek tutarı artırılmalı
Fuarda 77 ülkeden milli katılım organizasyonunun yer aldığını ifade eden Ege Maden İhracatçıları Birliği Başkanı İbrahim Alimoğlu, “ülkemizden katılan firma sayısını artırıp, ülke pavyonumuzu daha görkemli bir hale getirmemiz gerekiyor. Diğer 76 ülke karşısında öne çıkmak istiyorsak mutlaka katılımı azami seviyeye çıkarmalıyız. Bunun yolu da firmalarımıza Ticaret Bakanlığınca sağlanan desteği artırmaktan geçiyor. “ şeklinde konuştu.
Şanghay Konsolosluğunda düzenlenen 10 Kasım Atatürk’ü Anma Etkinliğine de katılım sağlandı.
Fuar kapsamında Şanghay’da bulunun heyetimiz, Başkonsolosluğumuzda düzenlenen, Yüce Önder Mustafa Kemal Atatürk’ü anma etkinliğine katıldı.
Fuara Birliklerimizi temsilen Ege İhracatçı Birlikleri Koordinatör Başkan Yardımcısı ve Ege Demir ve Demir dışı Metaller İhracatçıları Birliği Yalçın Ertan, Ege İhracatçı Birlikleri Sürdürülebilirlik ve Organik Ürünler Koordinatörü ve Ege Kuru Meyve ve Mamulleri İhracatçıları Birliği Başkanımız Mehmet Ali Işık, Ege Maden İhracatçıları Birliği Başkanı İbrahim Alimoğlu, Ege Hububat Bakliyat Yağlı Tohumlar ve Mamulleri İhracatçıları Birliği Başkanı Muhammet Öztürk, Ege Deri ve Deri Mamulleri İhracatçıları Birliği Başkanı Erkan Zandar, Ege Su Ürünleri ve Hayvansal Mamuller İhracatçıları Birliği Yönetim Kurulu Üyeleri Keskin Keskinoğlu, Mehmet Şahin Çakan ile Mesut Ergül katıldı.
Kaynak: (BYZHA) Beyaz Haber Ajansı
 İmsak Vakti 02:00
İmsak Vakti 02:00



 News
News
 DÜNYA
DÜNYA
 DÜNYA
DÜNYA
 DÜNYA
DÜNYA
 DÜNYA
DÜNYA
 DÜNYA
DÜNYA
 DÜNYA
DÜNYA
DÜNYA
DÜNYA
 ROPÖRTAJLAR
ROPÖRTAJLAR
 DÜNYA
DÜNYA
 DÜNYA
DÜNYA
 DÜNYA
DÜNYA
 DÜNYA
DÜNYA
 SİBER GÜVENLİK
SİBER GÜVENLİK























